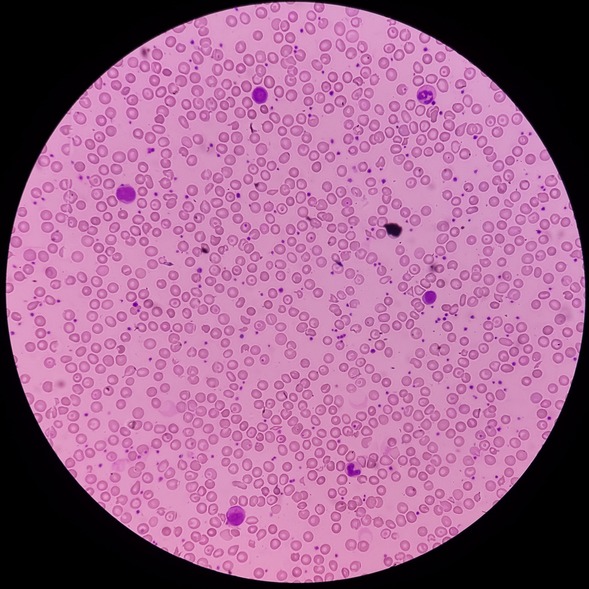
Illustrazione grafica per Sferocitosi (ittero emolitico di Minkowski e Chauffard)

La sindrome di X fragile, o sindrome di Martin-Bell, è una condizione genetica ereditaria che colpisce lo sviluppo cognitivo e comportamentale. È la forma ereditaria più comune di ritardo mentale e la causa genetica più comune di autismo.
La condizione può essere ereditata da uno dei genitori. Ad oggi, chi ne è affetto può beneficiare di una varietà di interventi educativi, comportamentali e medici mirati a migliorare la qualità della vita e ad affrontare le sfide associate.

La condizione può essere ereditata da uno dei genitori. Ad oggi, chi ne è affetto può beneficiare di una varietà di interventi educativi, comportamentali e medici mirati a migliorare la qualità della vita e ad affrontare le sfide associate.

 Cause
Cause
Causa della sindrome X fragile è una mutazione del gene FMR1, situato sul cromosoma X. Questo gene contiene istruzioni per la produzione di una proteina chiamata proteina del ritardo mentale fragile X (FMRP), che svolge un ruolo importante nello sviluppo e nella funzione del cervello.
Quando il gene FMR1 subisce una mutazione, può verificarsi una carenza o una mancanza di produzione di FMRP.
 Sintomi
Sintomi
I sintomi della sindrome X fragile possono variare notevolmente da persona a persona. Tra i più comuni si segnalano: - ritardo mentale: è la conseguenza più comune nei pazienti con sindrome X fragile e può variare in gravità;
- disturbi di apprendimento: il paziente potrebbe mostrare difficoltà nell’apprendimento di nuove informazioni e concetti, specialmente in ambito scolastico;
- problemi del linguaggio: il paziente potrebbe mostrare difficoltà nell’uso e nella comprensione del linguaggio, o essere interessato da ecolalia (ripetizione delle parole o delle frasi);
- comportamenti sociali atipici: si tratta della difficoltà nel comprendere e rispondere adeguatamente ai segnali sociali. Può manifestarsi con la tendenza a evitare il contatto visivo o le interazioni con gli altri o con l’adozione di comportamenti ripetitivi o stereotipati;
- iperattività e impulsività: si tratta della tendenza ad essere irrequieti, impulsivi o incapaci, per esempio, di restare seduti per lunghi periodi di tempo;
- ansia e problemi comportamentali: possono comparire comuni sintomi di ansia, nervosismo o difficoltà a gestire le emozioni, così come aggressività;
- disturbi del sonno: il paziente potrebbe avere difficoltà ad addormentarsi, soffrire di risvegli notturni frequenti o sonno agitato;
- problemi di coordinazione motoria: difficoltà nell’eseguire compiti che richiedono coordinazione e controllo motorio, come scrivere, correre o saltare.
 Diagnosi
Diagnosi
La diagnosi della sindrome X fragile coinvolge una combinazione di esami e test genetici. L’iter si articola generalmente come segue: - valutazione clinica: lo specialista inizia raccogliendo la storia clinica del paziente, esaminando i sintomi presenti e valutando lo sviluppo cognitivo, linguistico e comportamentale;
- test genetici: sono essenziali per la diagnosi della sindrome X fragile. Il test più frequente coinvolge tipicamente l’analisi del gene FMR1 per rilevare eventuali anomalie. Questo test può essere eseguito tramite un semplice prelievo di sangue;
- valutazione comportamentale: uno psicologo può condurre valutazioni comportamentali per valutare la presenza e la gravità dei sintomi cognitivi, linguistici e comportamentali associati alla sindrome X fragile;
- valutazione dello sviluppo: il paziente bambino può essere valutato per lo sviluppo del linguaggio, delle abilità motorie e sociali, nonché per eventuali ritardi o deficit nello sviluppo.

 Rischi
Rischi
La sindrome di X fragile può comportare una serie di rischi e complicazioni, capaci di influenzare diversi aspetti della vita di un individuo. Si segnalano: - ritardo mentale: la sindrome di X fragile è una delle principali cause ereditarie di ritardo mentale, con conseguenze sull’apprendimento e l’adattamento sociale;
- disturbi del linguaggio: il paziente potrebbe mostrare difficoltà crescente nello sviluppo, comprensione e uso del linguaggio;
- problemi comportamentali: possono presentarsi, e via via aggravarsi, comportamenti sociali atipici, quali, ad esempio, ansia, impulsività, iperattività e problemi di controllo delle emozioni;
- autismo e disturbi dello spettro autistico: la sindrome X fragile è una delle principali cause genetiche di autismo, con la quale condivide molti sintomi (es. difficoltà comunicative e di relazione sociale). Questi possono comparire anche in quei casi in cui la sindrome X fragile non ha causato autismo;
- problemi motori e coordinazione: alcuni individui con sindrome X fragile possono avere gravi problemi di equilibrio e coordinazione motoria, fino alla vera e propria inabilità;
- problemi di salute fisica: la sindrome X fragile potrebbe rendere i pazienti maggiormente suscettibili ad epilessia, disturbi del sonno, problemi gastrointestinali, anomalie del sistema cardiaco;
- impatto sulla famiglia e sulle relazioni: la gestione dei sintomi e delle esigenze di un individuo con sindrome X fragile può mettere a dura prova le risorse della famiglia e influenzare le relazioni familiari e sociali.
 Cure e Trattamenti
Cure e Trattamenti
Attualmente non esiste una cura definitiva per la sindrome di X fragile. Tuttavia, ci sono molte terapie e interventi disponibili per gestire i sintomi e migliorare la qualità della vita dei pazienti affetti e delle loro famiglie. Tra i principali approcci si segnalano: - interventi educativi e comportamentali: interventi educativi precoci e mirati possono aiutare i bambini con sindrome X fragile a sviluppare abilità cognitive, linguistiche e sociali compensative. Questi interventi possono includere terapie del linguaggio, terapie comportamentali e specifici programmi di apprendimento;
- terapie occupazionali e fisiche: le terapie occupazionali e fisiche possono essere utilizzate per migliorare le abilità motorie, la coordinazione e l’indipendenza quotidiana. Possono includere esercizi, attività di stimolazione sensoriale, strategie di gestione del comportamento e adattamento ambientale;
- farmaci: alcuni farmaci possono essere prescritti per trattare i sintomi associati alla sindrome X fragile come l’iperattività, l’ansia e, quando necessario, l’epilessia;
- supporto psicologico e familiare: è importante fornire supporto psicologico e emotivo ai pazienti affetti da sindrome X fragile e alle loro famiglie. I servizi di consulenza, il supporto dei gruppi di pari e le risorse educative possono aiutare le famiglie a comprendere la condizione e a gestire le sfide che comporta.
Bibliografia
- Salcedo-Arellano MJ, Hagerman RJ, Martínez-Cerdeño V. Fragile X syndrome: clinical presentation, pathology and treatment. Gac Med Mex. 2020;156(1):60-66. English. doi: 10.24875/GMM.19005275. PMID: 32026885.
- Protic DD, Aishworiya R, Salcedo-Arellano MJ, Tang SJ, Milisavljevic J, Mitrovic F, Hagerman RJ, Budimirovic DB. Fragile X Syndrome: From Molecular Aspect to Clinical Treatment. Int J Mol Sci. 2022 Feb 9;23(4):1935. doi: 10.3390/ijms23041935. PMID: 35216055; PMCID: PMC8875233.
- Salcedo-Arellano MJ, Dufour B, McLennan Y, Martinez-Cerdeno V, Hagerman R. Fragile X syndrome and associated disorders: Clinical aspects and pathology. Neurobiol Dis. 2020 Mar;136:104740. doi: 10.1016/j.nbd.2020.104740. Epub 2020 Jan 10. PMID: 31927143; PMCID: PMC7027994.
- Acero-Garcés DO, Saldarriaga W, Cabal-Herrera AM, Rojas CA, Hagerman RJ. Fragile X Syndrome in children. Colomb Med (Cali). 2023 May 20;54(2):e4005089. doi: 10.25100/cm.v54i2.5089. PMID: 37664646; PMCID: PMC10469670.
L'informazione presente nel sito deve servire a migliorare, e non a sostituire, il rapporto medico-paziente. In caso di disturbi e/o malattie rivolgiti al tuo medico di base o ad uno specialista.
Cerca i migliori specialisti che si occupano di Sindrome X fragileRevisione Scientifica

Hai bisogno di un Dottore per Sindrome X fragile?
Trova il Medico più adatto alle tue esigenze.
Hai bisogno di un Dottore per Sindrome X fragile?